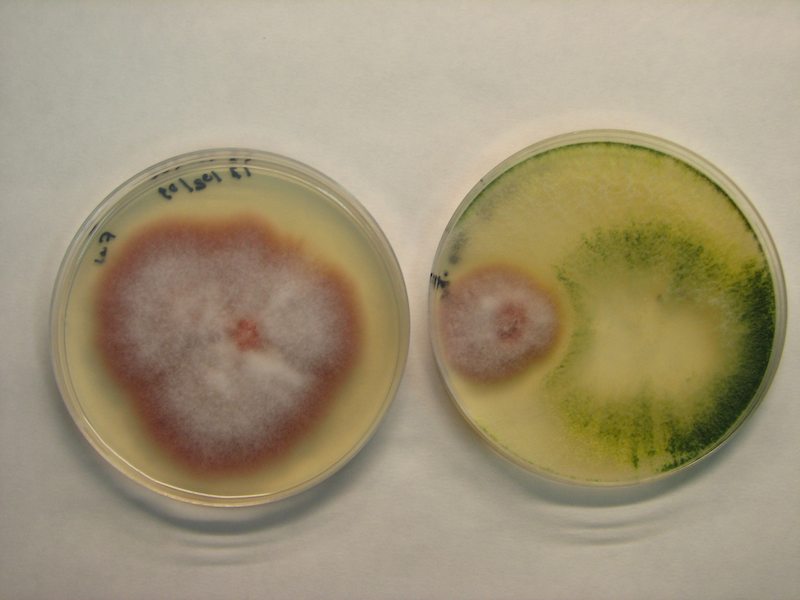
Nuevos sustratos “a la carta” basados en compostaje de residuos vegetales

Reciclaje y residuos
El Departamento de Medio Ambiente, ASEDAS y ASUPAR firman un convenio para reducir el uso de bolsas de plástico de un solo uso
Medio Ambiente recorrerá playas y centros comerciales para tratar de reducir las bolsas de plástico en un 50% en 2010-11